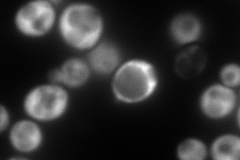
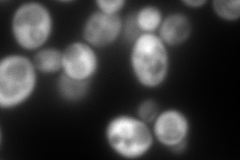
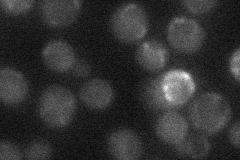
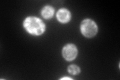

View description
Alpha subunit of the heteromeric nascent polypeptide-associated complex (NAC) involved in protein sorting and translocation, associated with cytoplasmic ribosomes
Localization:
Intensity:
Fold change:
Significance:
-
C’ GFP library in SD

cytosol552.1 -
N' NOP1pr-GFP in SD
cytosol318.31 -
N' TEF2pr-mCherry in SD
cytosol474.042 -
N' NATIVEpr-GFP in SD
below threshold20.4212 -
N' TEF2pr-VC and Cyto-VN in SD

cytosol49.4717 -
C’ GFP library in SD+DTT

cytosol617.991.11No -
C’ GFP library in SD+H2O2

cytosol469.50.85No -
C’ GFP library in Starvation Media
cytosol393.050.71No -
C’ GFP library on the background of Pup2-DaMP

cytosol -
C’ GFP library on the background of CCT mutant

cytosol519.3810.940718No
